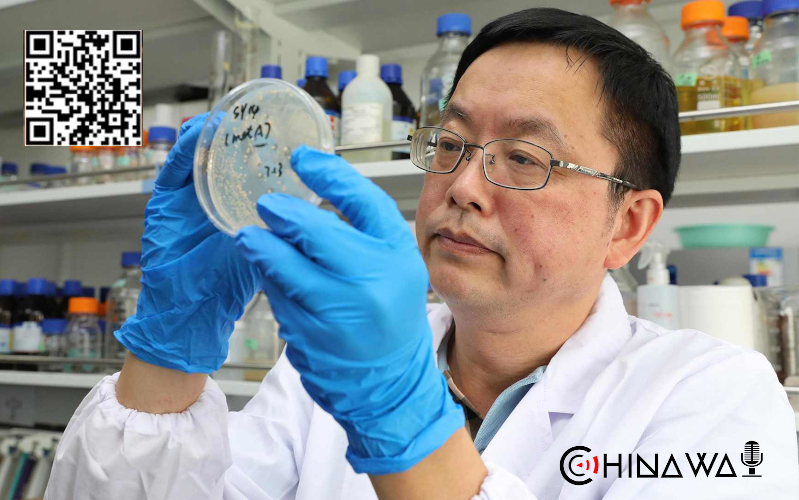
Ученые назвали долю бессимптомных носителей COVID-19

-

Китайскую блогершу оштрафовали на рекордные $210 млн за уход от налогов
admin
Власти Китая оштрафовали известную блогершу на рекордные $210 млн. Девушку, получившую известность за способность «продать что угодно» в ходе прямых трансляций, обвинили в уходе от налогов Налоговое ведомство китайского города Ханчжоу оштрафовало популярную стримершу Viya (реальное имя Хуан Вэй) на рекордные 1,34 млрд юаней ($210 млн) за уклонение от уплаты налогов, сообщает South China Morning Post. Налоговая…
-

В Китайской академии наук заявили о связи омикрон-штамма с лабораторным вирусом
admin
Штамм коронавируса Omicron вряд ли мог накопить такое количество мутаций, развиваясь только в человеческой популяции. Так считают ученые из Института генетики и биологии развития Китайской академии наук, которые провели специальное исследование. По словам специалистов, чтобы приобрести такое количество мутаций, омикронный штамм коронавируса должен был “перепрыгнуть” сначала в мышей, а затем обратно в человека. Китайские исследователи…
-

В Китае гробницу с «Терракотовой армией» просветят космическими лучами
admin
Для сканирования знаменитой запечатанной гробницей Первого Императора Китая Цинь Шихуанди планируется использовать космические лучи. Погребальный комплекс площадью 56 кв.км находится в районе Линьтун города Сиань, провинции Шэньси и, по слухам, содержит смертельные ловушки и древнюю карту с реками жидкой ртути. В числе прочего, гробница известна своей Терракотовой армией, которая охраняет императора после смерти. Тысячи когда-то…
-

Компания NIO представила в Китае электромобиль ET5 с запасом хода более 1 тыс. километров
admin
Cостоялась презентация стильного электромобиля NIO ET5, который позиционируется китайским автопроизводителем, как прямой конкурент Tesla Model 3. Что касается стартапов по производству электромобилей, компания NIO, похоже, движется в правильном направлении. Всего за пять лет, китайская компания по производству электромобилей выпустила пять моделей. Это впечатляющий подвиг, учитывая годы, которые компания работает в бизнесе. В настоящее время NIO…
-

В районе Пекина объявили карантин после обнаружения коронавируса у учащегося
admin
Строгие карантинные меры введены в воскресенье в пригородном районе Пекина Тунчжоу из-за положительного результата ПЦР-теста на коронавирус у учащегося. Как сообщает Центр по профилактике коронавирусной инфекции района Тунчжоу, инфицированный юноша занимался в художественной студии поселка Сунчжуан. В примыкающей к студии зоне введен режим ограничения передвижения населения, устанавливается источник заражения. Все близко общавшиеся с инфицированным помещены…
-
Ученые назвали долю бессимптомных носителей COVID-19
admin
Ученые Пекинского университета выяснили, какова доля бессимптомных носителей вируса среди людей с положительным результатом ПЦР-теста и подтвержденным диагнозом «коронавирус». Результаты исследования опубликованы в журнале JAMA network. Специалисты изучили 95 научных работ с данными более 29 млн пациентов, прошедших тестирование, и выяснили, что совокупный процент бессимптомных инфекций составил 0,25% среди протестированного населения и 40,50% среди населения с подтвержденным COVID-19. В работе подчеркивается, что…
-

Участникам Олимпиады в Пекине разблокируют доступ к заблокированным в Китае соцсетям
admin
Международный олимпийский комитет (МОК) сообщил, что оргкомитет Олимпиады в Пекине (Китай) предоставит спортсменам доступ к заблокированным в стране социальным сетям. «В соответствии с обязательствами, которые по контракту взял на себя город-организатор, оргкомитет зимних Олимпийских игр в Пекине предоставит внутри замкнутой системы открытый интернет-сервис всем аккредитованным участникам на ключевых олимпийских объектах, включая Олимпийские деревни, места проведения соревнований и внесоревновательных мероприятий, а также в отелях, где Wi-Fi будет доступен…
-

Карантин в Китае поставил под угрозу мировую экономику
admin
В одном из ключевых промышленных районов Китая остановили производство из-за вспышки COVID-19. Десятки предприятий ушли на карантин в провинции Чжэцзян, на которую приходится до шести процентов ВВП страны. Как сообщает Reuters, ограничительные меры в местных портах ставят под угрозу мировую экономику и грозят усугубить проблемы с морскими перевозками. Агентство уточнило, что как минимум 20 компаний, торгующихся…
-

Власти Китая оштрафовали Weibo на $470 тыс.
admin
Канцелярия по киберпространству КНР оштрафовала китайский сервис микроблогов Weibo (аналог Twitter) на 3 млн юаней (около $472 тыс.) за публикацию запрещенного контента. Об этом говорится в опубликованном во вторник сообщении на сайте ведомства. В документе отмечается, что с января по ноябрь этого года власти 44 раза налагали взыскания на компанию. Общая сумма выплаченных штрафов за…
-

Alibaba уволила сотрудницу, обвинившую начальника в домогательствах
admin
Китайский онлайн-ритейлер Alibaba Group Holding уволил сотрудницу, ранее обвинившую своего супервайзера в домогательствах во время командировки, пишет BBC. Причиной увольнения стало распространение сотрудницей ложных сведений, вредящих репутации компании, следует из документа об увольнении, который она предоставила государственной газете Dahe Daily. Судя по документу, сотрудница, известная как мисс Чжоу, покинула Alibaba в конце ноября. “Я не сделала ничего…
Поиск
Подпишитесь на нас
Рубрика
- Белый список (1)
- Бизнес новости (24)
- В мире (1 090)
- Досуг (483)
- Знаменитости (321)
- Интервью (3)
- История (3)
- Клипы (102)
- Культура (21)
- Медицина (7)
- Международное сотрудничество (2)
- Мода (7)
- Наука (19)
- Наши новости (312)
- Новости Китая (991)
- Новости спорта (820)
- Нужно знать (10)
- Общество (1 105)
- Полезные приложения (1)
- Полезные советы (50)
- Помощь (2)
- Производство (2)
- Происшествия (5)
- Путешествия (4)
- Работа (1)
- Развлечения (4)
- Рупор в Поднебесной (4)
- СМИ (2)
- События (14)
- Спорт (7)
- Тема дня (4)
- Техника (9)
- Технологии (173)
- Уроки китайского языка (8)
- Экология (2)
- Экономика (2)
Свежая запись
- Фейки на русско-украинской войнеАвтор: admin
- Русско-Украинская война, фактыАвтор: admin
- SAY NO WAR IN UKRAINEАвтор: admin
- В китайском McDonald’s установили велотренажеры для сжигания калорий во время едыАвтор: admin
- В КНР впервые создан цифровой прокурор, предъявляющий обвинения с точностью 97%Автор: admin



